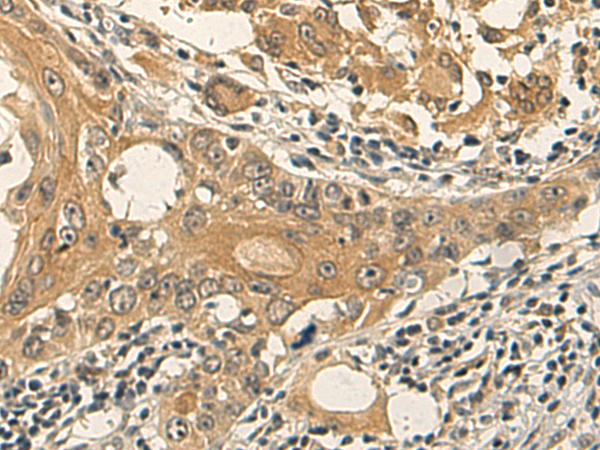
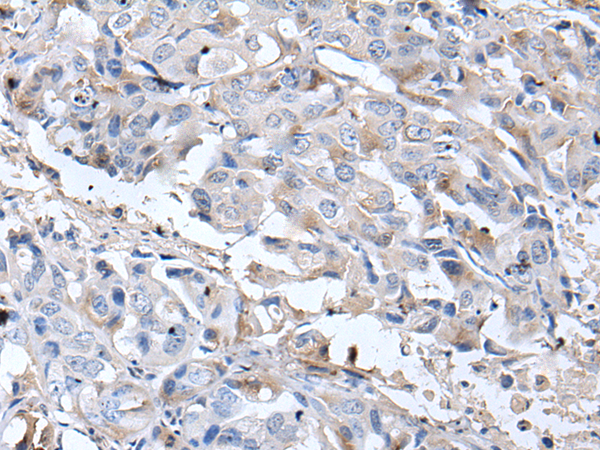
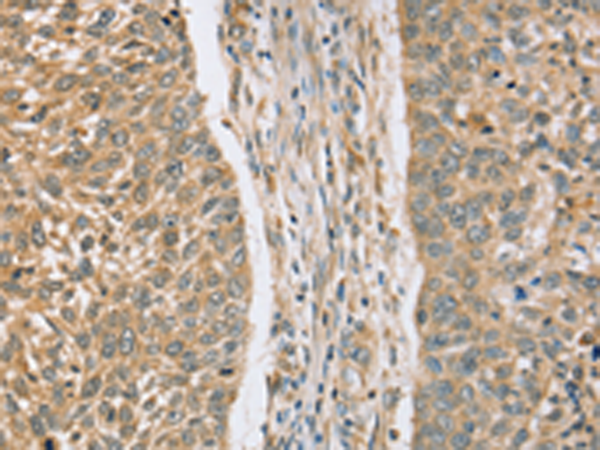
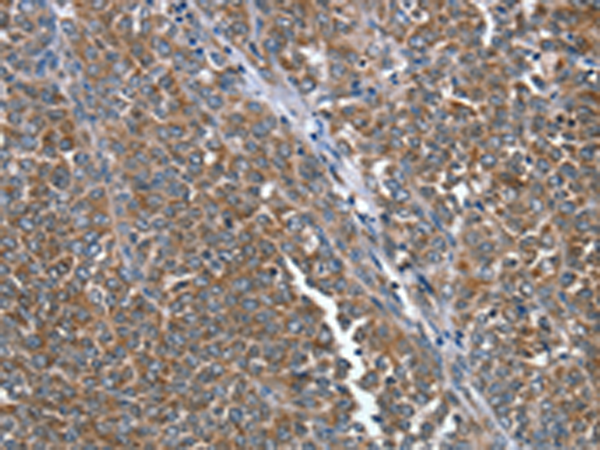

-
分类: 科研抗体货号: P08680别名: BOG; RBBP10应用: WB,IHC反应种属: Human, Mouse, Rat
-
分类: 科研抗体货号: P08679别名: RASSF5应用: IHC反应种属: Human, Mouse
-
分类: 科研抗体货号: P08661别名:应用: WB,IHC反应种属: Human, Mouse, Rat
-
分类: 科研抗体货号: P08678别名: PAMCI; PCIP1; P-CIP1应用: IHC反应种属: Human, Mouse, Rat
-
分类: 科研抗体货号: P08659别名: Q6; QSCN6应用: WB,IHC反应种属: Human
-
分类: 科研抗体货号: P08677别名: HOJ1; C12orf2应用: IHC反应种属: Human, Mouse
-
分类: 科研抗体货号: P08658别名:应用: WB,IHC反应种属: Human, Mouse, Rat
-
分类: 科研抗体货号: P08676别名: AD037应用: IHC反应种属: Human, Mouse, Rat
-
分类: 科研抗体货号: P08657别名: GSD6应用: WB,IHC反应种属: Human, Mouse, Rat
-
分类: 科研抗体货号: P08656别名: BIT1; PTH2; CFAP37; CGI-147应用: WB,IHC反应种属: Human, Mouse

鄂公网安备42018502007531号
鄂公网安备42018502007531号

